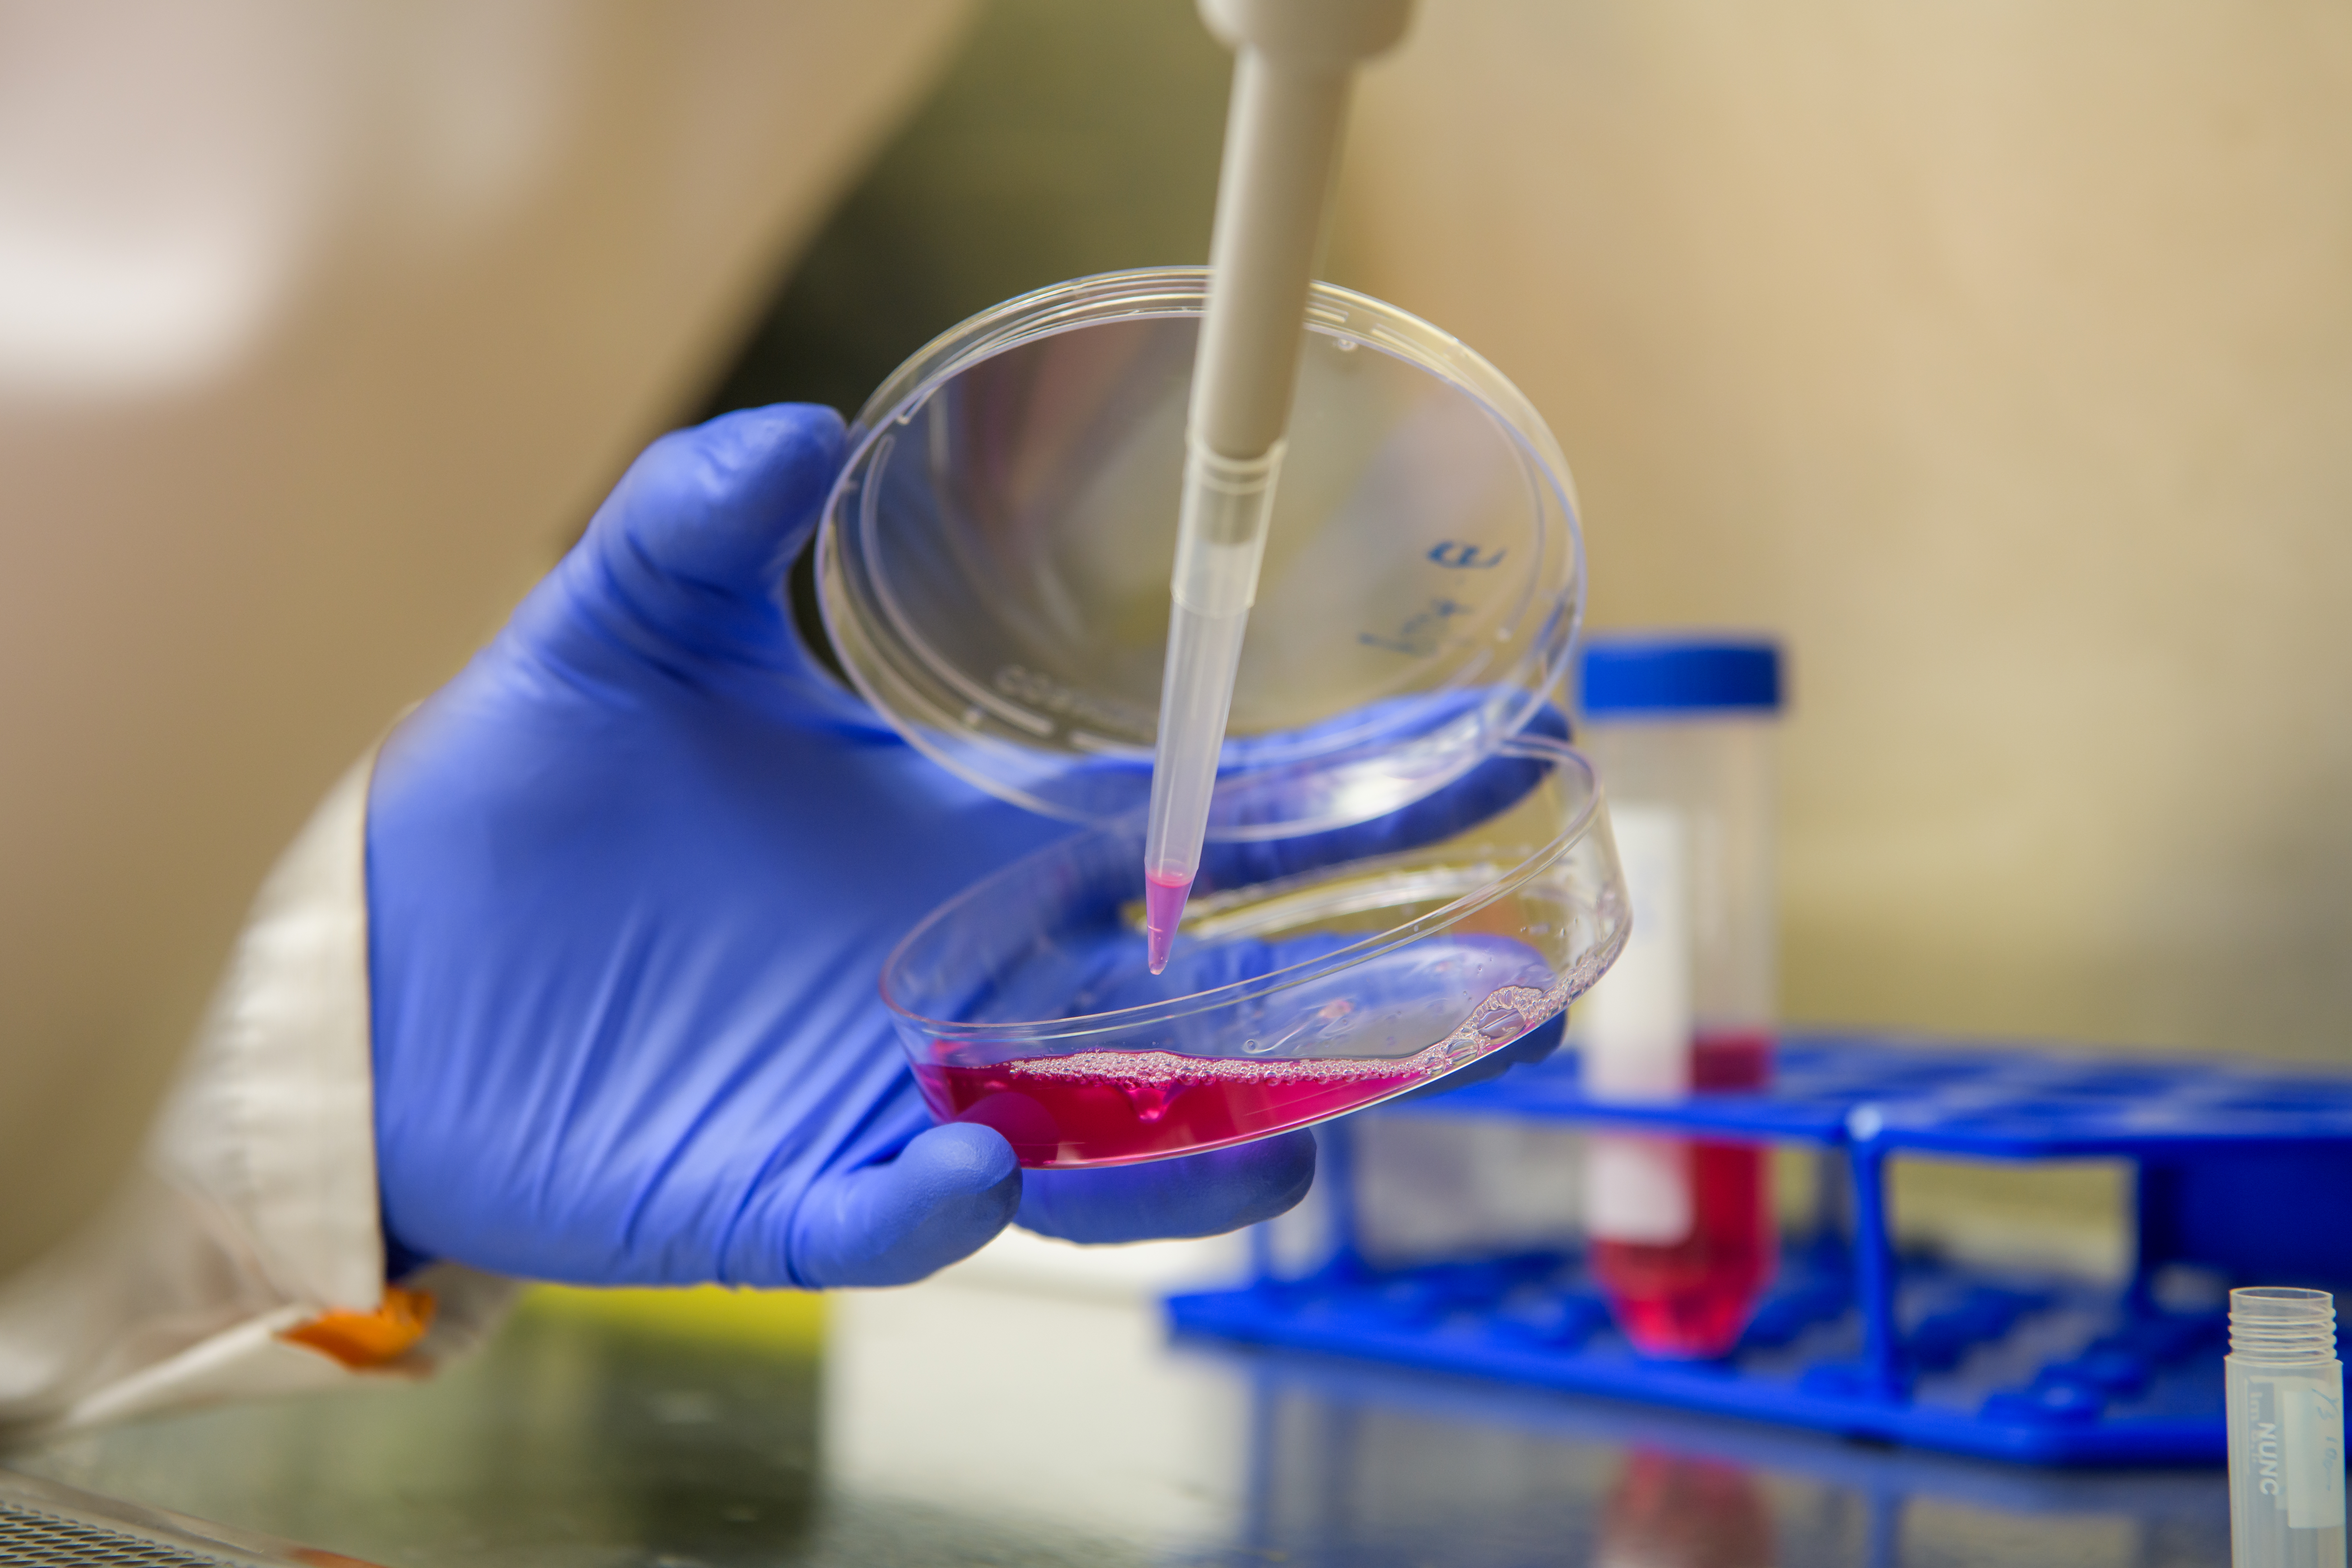

Improving human health by carrying out cutting-edge, fundamental basic and translational research focusing on the bacteria, viruses and parasites that cause human disease and the immune system that responds to these pathogens.
Infectious and immune-mediated diseases are the cause of significant human morbidity and mortality throughout the world. It is estimated that health care costs associated with the treatment of infectious, allergic and autoimmune diseases approach $240 billion dollars per year in the United States alone. With the ongoing globalization and urbanization of human populations, the incidence rates of allergic and autoimmune disease continue to rise and new/emerging pathogens continuously challenge our ability to prevent and control infectious disease outbreaks.
Thus, despite all of the wonderful advances in medicine, there is still a need to better understand the biology of the pathogens that cause disease, the mechanisms that the host uses to resist disease and the pathology that results from an inappropriate or insufficient response by the host immune system.